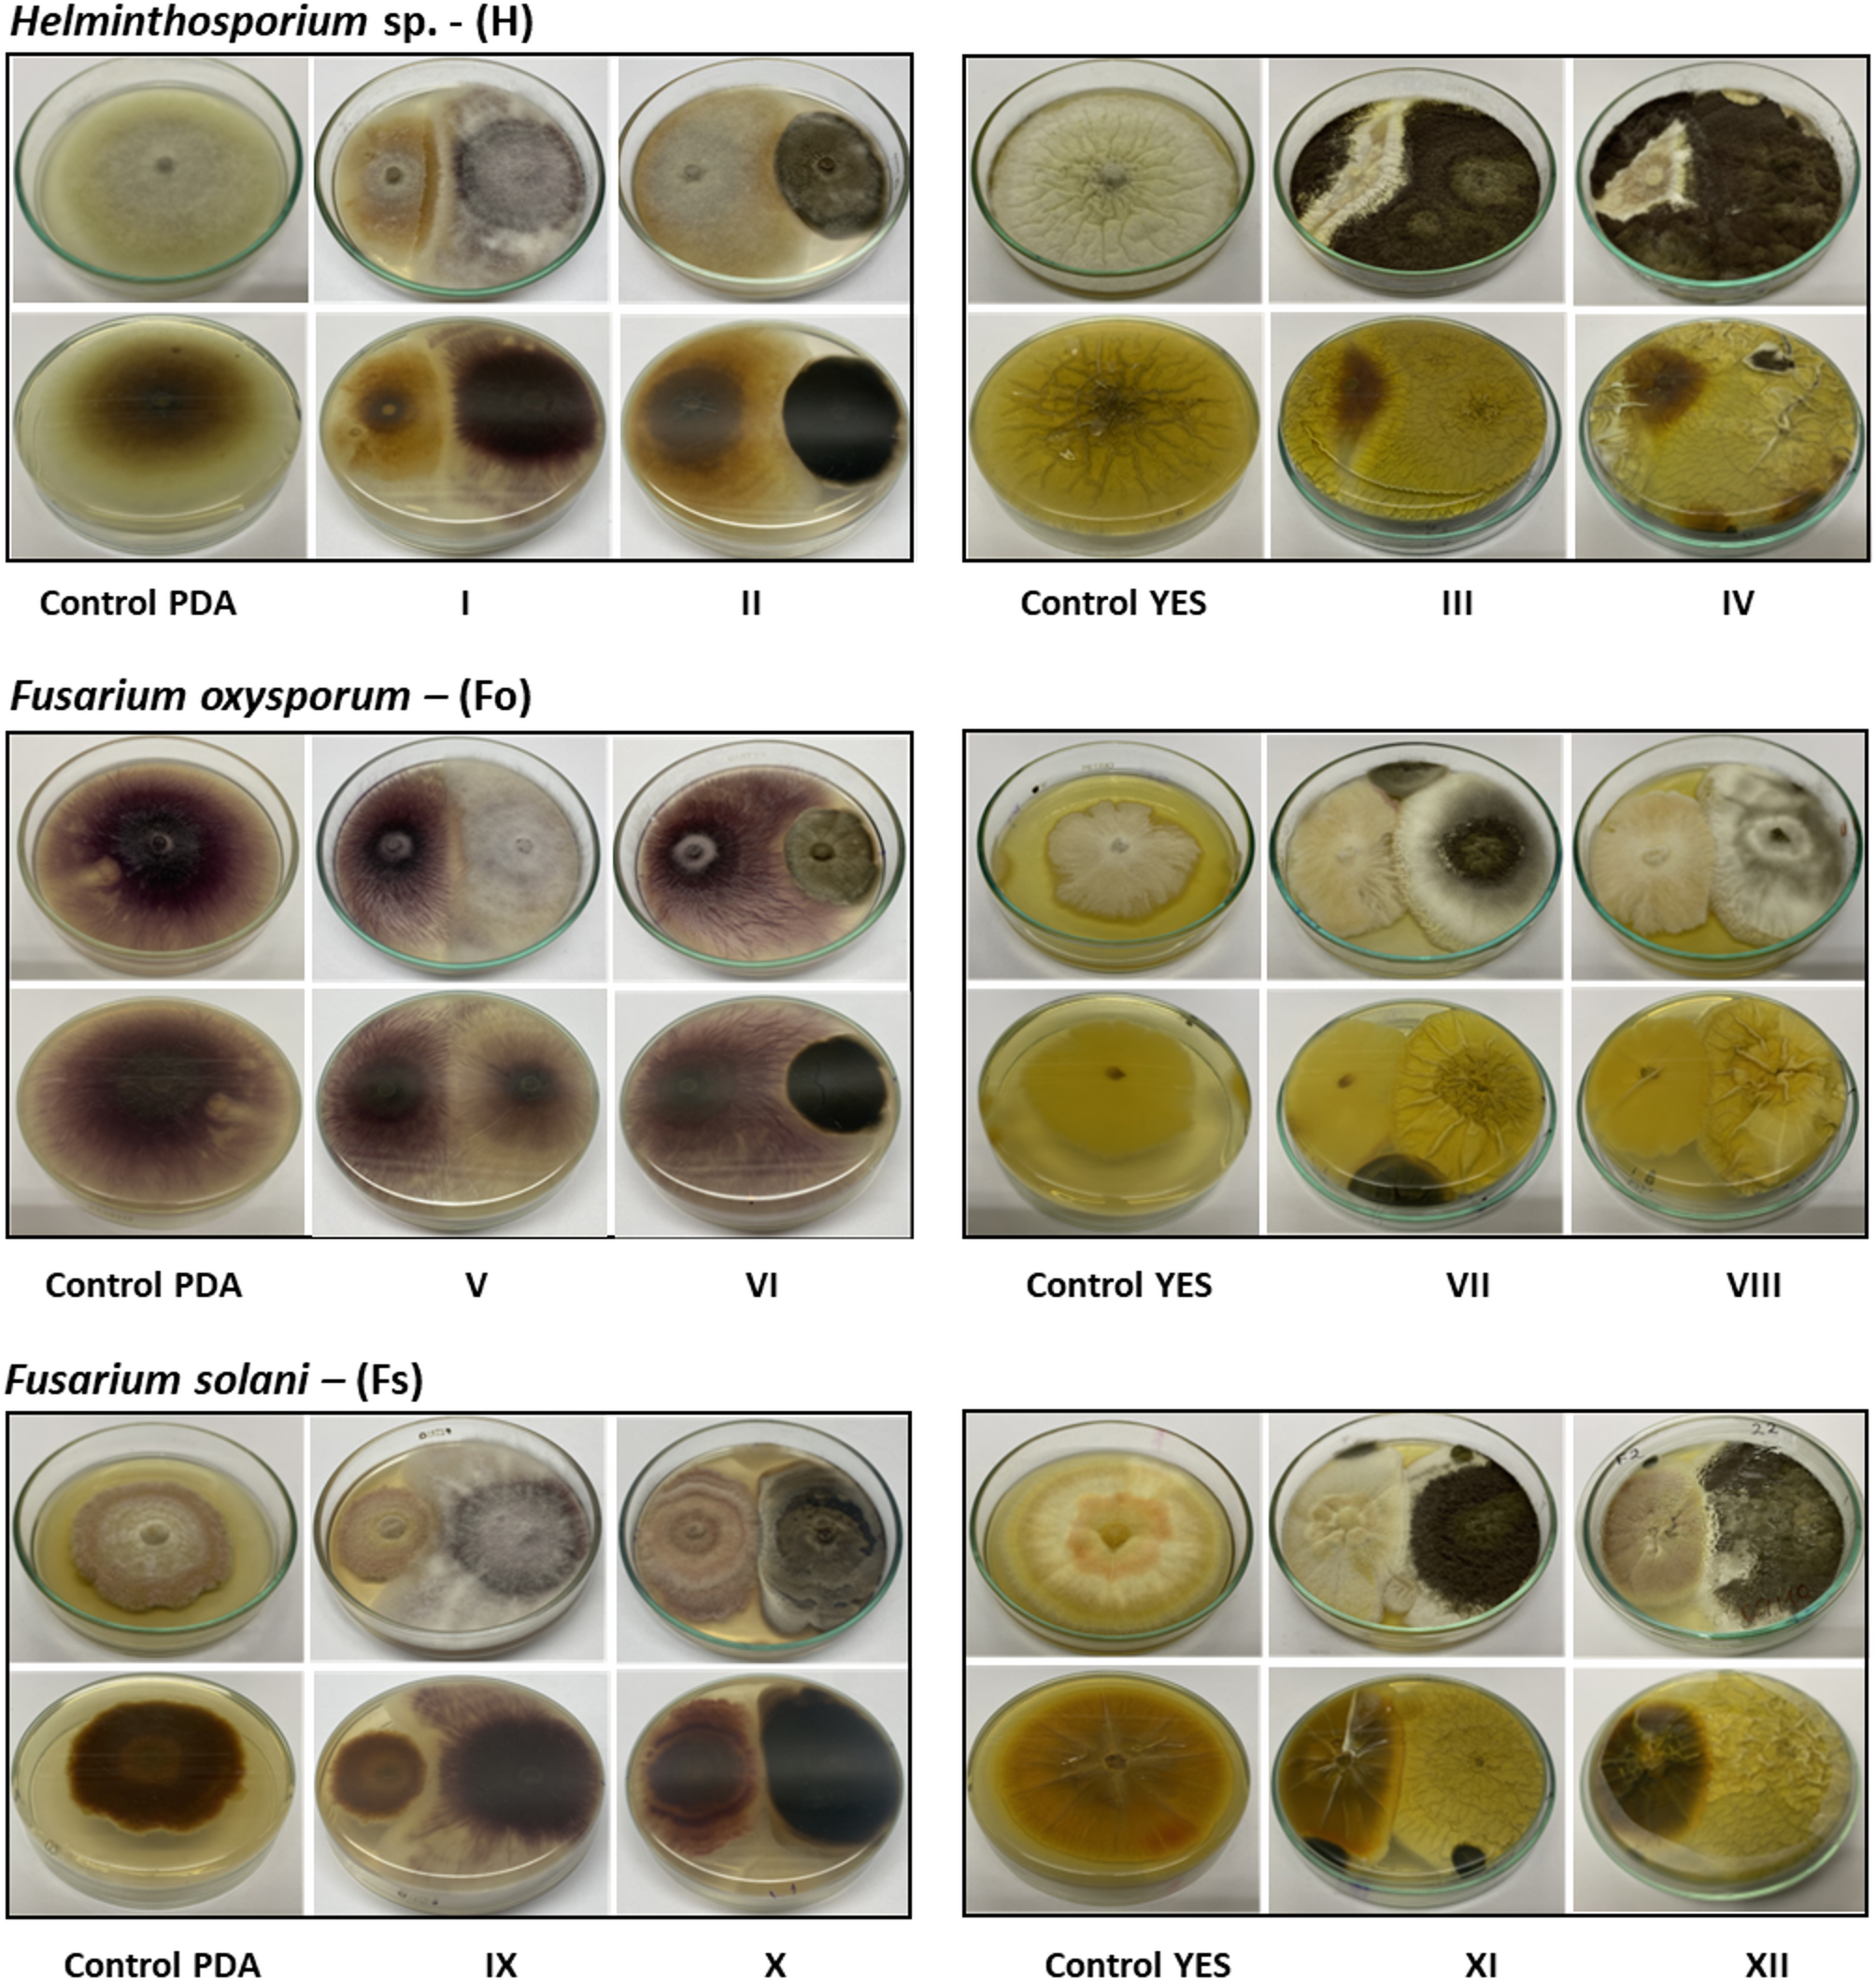
Fig. 8

Fig. 8
Direct confrontation of the endophytes Aspergillus sp. SMB-18, Fusarium sp. SMB-20, Aspergillus sp. SMB-22 and Alternaria sp. SMB-28 on the phytopathogens Helminthosporium, sp. (H), Fusarium oxysporum (Fo) and Fusarium solani (Fs). Confrontation of Fusarium sp. SMB-20 on PDA, on H (I), on Fo (V) and on Fs (IX). Confrontation of Alternaria sp. SMB-28 on PDA, on H (II), on Fo (VI) and on Fs (X). Confrontation of Aspergillus sp. SMB-18 on YES, on H (III), on Fo (VII) and on Fs (XI). Confrontation of Aspergillus sp. SMB-22 on YES, on H (IV), on Fo (VIII) and on Fs (XII).